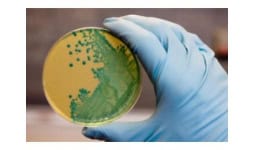

Encuentra aquí todo lo que necesitas relacionado al Sector Industrial: Metrología, Análisis y Control.
Si te interesa aparecer en la lista de proveedores del sector registra tu empresa con nosotros
Elige la imagen de tu interés, da clic y realiza una cotización directamente al proveedor o encuentra información de diversos proveedores y cotiza con todos llenando un solo formulario. Nuestros proveedores se contactarán directamente contigo sin costo ni comisión.
Los tomadores de decisiones están esperando para hacer negocios contigo.
Ponemos a tu alcance las oportunidades de negocio, mostrándote lo que nuestros compradores necesitan.
Conoce el comportamiento del mercado y haz negocio.
Cantidad: 1 Piezas
UNA (1) Turbina / blower interior evaporadora para minisplit Hisense modelo AU362VQ de 3 toneladas,...
CDMX, México
Cantidad: 1 Envío
hola buenas tardes me gustaria solicitar una cotizacion para una camara duplex de refrigeracion y...
Estado de México, México
Cantidad: 2 Piezas
Ocupo cotización de 2 piezas SMART PROBE TESTO 549i manometro de presion
Estado de México, México
Cantidad: 1 Envío
Tendran cable TKD 1000581 OPVC-JZ 5G0,75 mm2 400 metros 1 tramo Quedo...
La Libertad, Perú
Cantidad: 6 Piezas
solenoide MIDLAND modelo DN05-2435-17730 Me gustaría obtener una cotización para 6 unidades del...
Campeche, México
Cantidad: 1 Equipos
Importante empresa de Sabores. Urge rentar una Cámara de Congelación por corto tiempo. La necesito...
CDMX, México
CDMX, México
Cantidad: 1 Piezas
Cromatógrafo de gases-Espectrómetro de masas a) Descripción funcional del bien: Cromatógrafo de...
CDMX, México
Cantidad: 1 Envío
buenas tardes me gustaria realizar una cotizacion de unos productos ya que nuestro proyecto fue...
Tabasco, México
Cantidad: 1 Equipos
Espectrómetro de absorción atómica. Equipo con flama únicamente, con instalación en el cp...
Baja California, México
Baja California, México
Cantidad: 1 Envío
Buen dia me encuentro buscando este material : jack RJ45, y Tapa para jack de una ventana de...
Querétaro, México
Cantidad: 1 Envío
Por parte de Agua1954, solicitamos cotización de botellas de vidrio Borgoñera de 375 ml como las que...
Guanajuato, México
Cantidad: 1 Envío
CABLE DE CONTROL BLINDADO MULTINUCLEO CALIBRE 26 AWG 2 POLOS 100.00 METRO CABLE DE...
CDMX, México
Cantidad: 1 Piezas
Hola me podria cotizar 1 unidad de Homogenizador poligonal con capacidad de 100kg inox.304 tablero...
Baja California Sur, México
Cantidad: 1 Envío
Manómetro # 1 (entrada): presión positiva: (0 a 800) Psi Manómetro # 2 (salida): presión positiva:...
CDMX, México
Cantidad:
Me gustaría solicitar una cotización de dos calibraciones en sitio, la marca de los medidores es...
Nuevo León, México
Morelos, México
Cantidad: 1 Envío
Solicito cotización de Tonillos Requiero hablar con alguna persona de ventas urgentemente
San Luis Potosí, México
Cantidad: 1 Piezas
¿Manejan tarjeta para minisplit marca AURUS?
Nuevo León, México
Cantidad:
Solicito cotización de la siguiente tuberia: TUBERIA RD35 DE 4” ------- 20 TRAMOS TUBERIA RD35...
Quintana Roo, México
Jalisco, México
Cantidad: 1 Envío
CABLE DE COBRE SUAVE CON AISLAMIENTO PVC TIPO THHW-LS cal 12 AWG color negro y CABLE DE COBRE SUAVE...
CDMX, México
Tamaulipas, México
Conoce Ofertas, saldos, remates, excedentes de inventario y promociones de diversos proveedores del sector Metrología, Análisis y Control.
Mantente a la vanguardia leyendo los artículos de blog publicados por Cosmos Online y diversos proveedores relacionados al sector de Metrología, Análisis y Control, podrás encontrar información sobre Tendencias, Innovaciones, Regulaciones, Productos Y Servicios, Industrias y mucho más…
Te presentamos una guía técnica para elegir la opción correcta de las diferentes versiones de válvulas de globo para la industria.
Los drones industriales representan una ventaja competitiva para las empresas que buscan reducir costos, aumentar la seguridad.
Si estás pensando en cambiar tus equipos HPLC, aquí te damos consejos que te llevarán a tomar la mejor decisión.
Si deseas mantener tu equipo analítico en buen funcionamiento, conoce la importancia del mantenimiento preventivo de cromatógrafos de gases.
Te explicamos por qué digitalizar documentos dentro de una organización o empresa, y qué obtienes para la eficiencia de tu negocio.
Te explicamos qué buscar al contratar un servicio de digitalización de documentos para tu empresa para que elijas la mejor opción.
Descubre cómo el correcto funcionamiento de las columnas de cromatografía garantiza mejores resultados de análisis en diferentes industrias.
Descubre la importancia actual de la cromatografía de iones en la industria y los procesos de análisis específicos en los cuales ha sido impulsada
Con un ritmo de producción con enfoque en la eficiencia energética y la automatización, los cables de control son clave en la optimización de procesos industriales. Conoce más aquí.
Elegir el filtro tipo Y adecuado es crucial para la eficiencia y durabilidad en tus sistemas de tuberías, por eso te compartimos recomendaciones.
Compartimos diversas recomendaciones sobre cómo elegir al distribuidor adecuado de válvulas check y qué tomar en cuenta.
Te damos una guía para elegir la válvula check adecuada para tu proceso que asegure la eficiencia, seguridad y longevidad de tus sistemas.
El análisis de vitaminas es muy importante para diferentes sectores como el alimentario o el farmacéutico, y el mejor método es mediante cromatógrafos de líquidos, te indicamos porqué.
Si buscas necesidades superiores de embalaje para mercancía delicada, irregular, o de gran formato, conoce la tecnología de las pistolas retractiles.
Conoce la importancia de los cromatógrafos de líquidos para el análisis de miel que evalúan la calidad y composición natural de dicho producto.
Conoce la importancia del uso de registradores de datos en los procesos industriales y evita pérdidas en tus operaciones.
El aluminio (Al) puede ser un contaminante importante en alimentos y medicamentos, por eso, aquí podrás descubrir el método de análisis por espectrofotometría de absorción atómica recomendado.
El arsénico es un compuesto tóxico que puede encontrarse en el pescado y otros alimentos de origen marino. Por ello, es muy importante realizar un análisis y determinar el contenido de este elemento...
En este post hablaremos de los sensores de proximidad sin contacto y sus aplicaciones y características ¡No te lo pierdas y descubre cuál es el más adecuado para tu proceso y producto!
El análisis de metales en aceites lubricantes es fundamental para el mantenimiento de la maquinaria; para ello; se utiliza el equipo ICP-OES para cumplir con la norma ASTM D5185.
La espectroscopía de absorción atómica es el método ideal para la determinación de metales en bebidas alcohólicas, incluyendo mezcal. Aquí explicamos el método.
Los fugómetros para pruebas de hermeticidad son un equipo clave para el control de calidad de piezas en donde evitar fugas es fundamental para el funcionamiento del producto.
En el mercado existen opciones de servomotores que pueden reducir costos y tiempos de producción. Estos equipos se distinguen por su alta precisión, bajo nivel de vibración y afinación sencilla.
Los variadores de frecuencia son dispositivos fundamentales para el control y automatización de las líneas de producción de la industria farmacéutica, especialmente para los sistemas HVAC. Conoce más...
El diagnóstico fitosanitario es una herramienta fundamental para cuidar de los cultivos, gracias a la información que brindan es posible tomar decisiones sobre el tratamiento de enfermedades en...
Los sistemas pick-to-light son ideales para empresas que quieren automatizar sus operaciones de surtido o aumentar su productividad.
Los muebles para laboratorio son elementos indispensables para la conformación de un laboratorio, su correcta elección optimizará los espacios y las operaciones.
Conoce las ventajas de calibrar básculas industriales con el equipo profesional adecuado
Conoce los materiales utilizados en la fabricación de válvulas reguladoras para que elijas el material ideal para tu proceso
Hablamos sobre cuáles son las tendencias en equipos de medición industriales hacia la automatización para obtener procesos más eficientes.
Cuáles son los factores tomar en cuenta al elegir el equipo de medición industrial más adecuado para tu empresa.
Los analizadores Raman son dispositivos analíticos con características de valor para el sector farmacéutico en la producción de medicamentos, conoce porqué invertir en ellos.
Las lainas apoyan la calidad operativa de tu empresa y evitan preocupaciones por mantenimientos constantes y costosos, conoce cómo.
Los sensores para el mercado industrial están disponibles en una amplia gama, cada uno ofrece soluciones especiales, aquí te decimos cuáles.
Hablemos de sensores magnéticos, cómo funcionan y en donde son más usados.
Los arrancadores de estado sólido protegen a los equipos que están en operación dentro de un proceso dentro la industria.
Conoce la importancia de los sistemas de almacenamiento y cuáles son los aspectos que deben considerar para elegir el más adecuado
El aire comprimido contaminado eleva los costos operativos de una planta y afecta calidad y productividad. Los filtros para aire comprimido son la solución.
Descripción de los tipos de sensores fotoeléctricos, sus ventajas y desventajas y sus aplicaciones industriales.
Medir de forma profesional, con la finalidad de obtener datos y estadísticas, requieren de precisión y monitoreo
Para los tableros, los cables de control son las “venas” en los procesos de automatización, estos trasportan señales eléctricas de baja potencia
Las columnas capilares empleadas en la cromatografía de gases y gas-líquido son tubos de gran longitud y diámetro muy pequeño.
Un rotámetro es un medidor de flujo de área variable diseñado para medir el caudal de líquidos y gases. Conoce más aquí.
Los medidores de flujo, también conocidos como medidores de caudal, flujómetros o caudalímetros, son instrumentos para fluidos diversos.
El suministro de aire comprimido es tan importante en para la automatización industrial que se le considera un cuarto servicio básico
Las aplicaciones de la espectroscopia van desde la medición de velocidades de reacciones enzimáticas y cuantificación de concentraciones
La cromatografía de gases es una técnica de separación de mezclas químicas usada en el sector productivo para determinar la calidad
Para la implementación y certificación de esta nueva versión habrá un periodo de transición que concluye en septiembre de 2018.
El multímetro es un instrumento de medición que combina varias funciones en una sola unidad; se utiliza para medir diferentes parámetros
Debido a las múltiples aplicaciones que los manómetros tienen existen varios tipos que se adecuan a las necesidades de cada usuario
El estudio detallado de los componentes de células, tejidos animales y otras partículas que no puede percibir el ojo humano requiere
Las cámaras termográficas, dispositivos que permiten inspecciones en lugares difíciles donde no es posible colocar instrumentos convencionales
Un centro de mecanizado CNC es una máquina altamente desarrollada capaz de maquinar materiales con gran precisión y productividad
En esta segunda parte analizaremos las herramientas que nos ayudarán a mejorar la calidad de los servicios
Para controlar un proceso y darle seguimiento es necesario recabar datos, una de las tecnologías más importantes para tal fin es el data logger
La calidad en el servicio es un bien intangible que toda empresa debe desarrollar para satisfacer a sus clientes. La cultura de servicio
La tecnología biométrica es una herramienta automatizada de alta confiabilidad para identificar a los seres humanos, que se ha hecho muy útil
Las certificaciones verifican instalaciones y áreas, sanidad animal, bioseguridad, buenas prácticas en el uso de medicamentos veterinarios
Las atmósferas industriales contienen partículas en suspensión y a veces gases tóxicos producidos por las actividades que se realizan
Discutiremos sobre las nuevas técnicas que permiten aumentar la vida útil y con ello mejorar las operaciones de distribución y almacén
Una herramienta electrónica imprescindible para el control de los procesos industriales son los detectores, también conocidos como sensores.
La trazabilidad en la cadena de suministro es un concepto esencial para cualquier empresa que quiera ser competitiva en la industria
Discutiremos del concepto de vida útil y su importancia en la industria alimentaria y ahondaremos sobre nuevos métodos para alargar la vida útil
La demanda de agua purificada para beber es gigantesca, y en México está generando una gran cantidad de desperdicios, ya que somos el país con mayor consumo de agua embotellada en el mundo.
El marcado por láser, también conocido como grabado por láser, es una tecnología que utiliza la luz del láser con un diámetro de punto fino
La manufactura esbelta es un conjunto de herramientas que ayudan a eliminar las operaciones que no le agregan valor al producto
Diseñado por Alexander Osterwalder, el Modelo de Negocios Canvas permite crear un plan de empresa adaptado a los tiempos actuales
Como se ha mencionado en los temas anteriores ("Comprendiendo la Reforma Energética" parte 1 y 2) se enlista una serie de leyes que se modificaron, eliminaron o se introdujeron.
Cuando una empresa ofrece un bien y/o servicio, no es tan solo el producto en sí el que se vende, sino las características que lo diferencian
El comportamiento de la economía de México en el último año ha tenido una tendencia negativa, incluso por debajo de la esperada
Las videocámaras presentan innovaciones en cómo captan sus imágenes, de manera que ahora pueden distinguirlas fácilmente en la noche.
Cuando llega el mes de diciembre se comienza a hablar del aguinaldo, el cual es una prestación que se espera recibir conforme a la ley
Al transformar los artículos constitucionales para la apertura de capital privado y tecnología, se requieren normas que permitan una apertura
En la actualidad la reforma energética es un tema de gran importancia y es analizado constantemente desde distintos puntos de vista
Cuando se habla de las pequeñas y medianas empresas (pymes) se contemplan distintos aspectos como procesos productivos
En general, se deben usar cuando existe la posibilidad de caída de objetos (en construcciones, almacenes y trabajos que requieren
En otras palabras, el licenciamiento es un acuerdo de negocio mediante el cual una compañía le otorga a otra el permiso para manufacturar
Los criterios para la evaluación y selección de inversiones deben satisfacer las siguientes condiciones: resumir en un solo dato (una cifra)
Etimológicamente, riesgo es todo aquello que puede generar un evento no planeado y traer como consecuencia una perdida y un daño
Uno de los grandes retos que hay en materia de emprendimiento es el de desarrollar empresas innovadoras de alto impacto que puedan generar
El correo electrónico se suele utilizar más que antes y es el medio nuevo más popular. (Casi) todo el mundo usa el correo electrónico
La seguridad industrial es regulada por diversas normas que están contenidas principalmente en la Constitución Política, la Ley Federal del Trabajo
Este es un proceso biológico en el cual los microorganismos son los responsables de la degradación biológica de los contaminantes
El GPS (Global Positioning System) es un sistema de posicionamiento global, para su funcionamiento interactúa una red de satélites
La seguridad no es un elemento nuevo, desde la antigüedad las personas han cuidado sus pertenencias y se han ideado cientos de formas
El enfoque de la mercadotecnia no se debe asociar directamente con el sentido antiguo de las ventas, más bien, con la finalidad de satisfacer las necesidades
Para que un negocio tenga éxito, no solo se necesita una idea innovadora, generalmente conlleva la necesidad de establecer una relación con más personas (socios)
Cerca del 60 por ciento de los profesionistas mexicanos considera a sus superiores como líderes porque ven en ellos a una persona llena de entusiasmo
Existe una nueva tendencia que apela a la financiación popular para atraer capital y poder financiar algún proyecto o idea de negocio
Desde la década de los 60 las empresas se han beneficiado con la tecnología y esta ha evolucionado para ser cada vez más competitiva
La principal columna vertebral de la economía nacional son las micro, pequeñas y medianas empresas (PYMES), según el Instituto Nacional de Estadística y Geografía
El neopreno es un hule sintético que se mantiene flexible incluso al ser sometido a gran presión o a temperaturas muy altas o bajas y como aislante, lo cual lo vuelve un material muy versátil...
Llamamos ácido acético glaciar al producto en concentración de 99.8% mínimo, lo que hace la diferencia con algunas presentaciones que manejan la solución del producto y por lo tanto...
Uno de los productos más utilizados para incorporar fósforo a los cultivos es el ácido fosfórico; el cuál, suele comercializarse en diversas concentraciones como un líquido transparente de...
El ácido nítrico es uno de los productos químicos más importantes a nivel mundial, pues sus aplicaciones están ampliamente extendidas en diversos sectores industriales.Se trata de un...
A través del gran número de solicitudes y requerimientos de Ácido Nítrico que hemos atendido en México, nos hemos percatado de que existen algunos elementos comunes que son de interés...
De acuerdo con el Sistema Nacional de Vigilancia Epidemiológica, en México el 56% de las quemaduras suceden en adultos en un rango de edad de 20 a 50 años y, de esta cifra, el 85% de los...
Los controladores de temperatura en los procesos industriales son un importante aporte para el control de las operaciones, sin que existan trabajadores monitoreando los parámetros térmicos que se...
Sustentabilidad de los plásticosEn artículos anteriores, hemos cubierto las tendencias de la industria del empaque y el empaque. La industria cuya producción beneficia a los fabricantes de materiales...
Contar con aire acondicionado es una gran necesidad de confort en muchos lugares con climas extremos. Sin embargo, todos los sistemas HVAC en funcionamiento van recolectando polvo, bacterias, virus,...
Hoy en día la innovación es un factor clave en el desarrollo de cualquier área o empresa por lo que se tienen que ocupar de avanzar y adaptarse con nuevas herramientas o materiales.Para ello, se...
Cuando una empresa de paquetería o cedis transita hacia la expansión de sus actividades, es necesaria tecnología de vanguardia. Una herramienta imprescindible es el software WMS.Este...
Los equipos de aire acondicionado son una pieza clave para brindar confort en determinadas áreas ya sean industriales, residenciales y oficinas, por ello es necesario garantizar un buen...
Gracias al equipo láser D320i de DominoMR se logró satisfacer las necesidades del cliente, este modelo brinda un rendimiento mejorado y líneas de texto ilimitadas. Asimismo, la calidad de...
En altas y bajas temperaturasNeopreno WDEl policloropreno es un elastómero versátil debido a que posee un gran número de propiedades que lo hacen adecuado para varias aplicaciones. Principalmente...
En los últimos años, los minisplits se han convertido en una opción popular para la refrigeración y calefacción de los hogares y oficinas. Además de ser más eficientes en el uso de la energía...
Hablando de…marcado con tinta en costal La industria cementera se vio afectada en su producción en los años de pandemia y aunque aún...
La calidad de los acabados en las manufacturas de autos, aeronaves y maquinaria forma parte del éxito de sus marcas. Las cabinas de pintura fueron diseñadas para los procesos de pintado sobre...
Equipos UPS, Baterías Selladas Libre de Mantenimiento, Plantas de Emergencia, Transformadores, Proyecto Eléctrico, Paneles Solares, Calentadores Solares, Integración de Redes Voz y Datos,...
Te ofrecemos el suministro y la instalación de estos equipos de respaldo y plantas de Emergencia. Igualmente, puedes contratar con nosotros el mantenimiento de plantas eléctricas y equipos UPS tanto...
¿Qué servicios puedes tomar con ATE?Te ofrecemos el suministro y la instalación de equipos de respaldo como Plantas de Emergencia, UPS (UNINTERRUPTED POWER SUPPLY). Igualmente, puedes contratar con...
Si quieres que los procesos productivos de tu empresa funcionen sin parar, conoce cómo lograrlo gracias a las plantas eléctricas.Las empresas deben garantizar que sus procesos productivos se realicen...
Hablando de…codificado de 5” México es el segundo país con mayor consumo de dulces en Latinoamérica con 4.5Kg anualmente por persona, esta demanda...
México es uno de los países con gran cantidad de fabricantes de confitería, en este sector entran una gran variedad de productos, tales como caramelos, productos de chocolate, productos de...
Muchas veces cuando las marcas desean reposicionarse crean campañas publicitarias con rifas o sorteos, en las cuales involucran a sus clientes y a su vez generan un aumento en la compra de los...
Hablando de…automatización segura con equipos DominoMuchas empresas buscan las mejores tecnologías y herramientas para sus colaboradores, además de ofrecer un mejor servicio a sus clientes, buscan que...
Introducción:La industria de la construcción es un sector que evoluciona constantemente, por lo que la búsqueda de materiales eficientes y versátiles es fundamental para el éxito de los...
México, un país situado en una región sísmicamente activa, ha experimentado a lo largo de su historia una serie de temblores devastadores que han dejado una marca indeleble en la memoria...
Hablando de…actualización de sistemas de visiónPara la industria farmacéutica es muy importante el asegurar que el 100% de sus productos salgan al mercado correctamente codificado, es decir,...
Los geofísicos utilizan modelos numéricos como herramientas fundamentales en su investigación para simular una amplia gama de fenómenos geofísicos y predecir su comportamiento. Estos modelos son...
¡Potencia tu Negocio con Energía Confiable!¿Por qué elegirnos?Experiencia Local: Con más de 14 años en el mercado, entendemos las necesidades específicas.Expertos en Energía: Nuestro equipo de...
¿Qué tiene Galvanoquímica que no tienen las demás empresas de productos químicos? Contamos con nuestra flotilla de camiones, con todos los permisos de la Secretaría de Comunicaciones y...
Una importante empresa dedicada a producir y empacar material de curación localizada en Puebla buscaba una solución para poder codificar directamente en las gasas.Había presentado problemas con su...
Para un líder en la producción de bebidas, la implementación del concepto “label-less” en sus líneas de producción representaba un reto tecnológico, ya que, al eliminar etiquetas, también...
En 2022, el intercambio comercial total de cables y demás conductores eléctricos aislados en México fue de más de 560 millones de dólares. La necesidad de este mercado es la de marcar de manera...
MONITOREO DE UN UPS El monitoreo es el proceso de recopilar, analizar y utilizar información para seguir el progreso del programa. Se trata de una función cíclica que implica la recopilación...
Hablando de…equipos en rentaA lo largo de los años, los sorteos han evolucionado desde simples estrategias de marketing hasta sofisticadas...
México se ubica entre los 11 principales productores de cacao a nivel internacional. De la producción total de cacao mexicano, solo el 44% está destinada a satisfacer la demanda nacional, por lo que...
Sabias que…El cartón corrugado es la principal materia prima que se utiliza para la fabricación de empaques y embalajes, gracias a sus múltiples beneficios que aporta en los procesos de...
RetoUna empresa en crecimiento ubicada en Tijuana, dedicada a la producción y montaje de maquillaje; Estaba buscando una...
Reto Una empresa ubicada en Tijuana, que se dedica a la fabricación de productos para higiene personal y codifica sus empaques, solicitaba cambiar el uso de etiquetas en sus...
Reto Una conocida empresa que se dedica a la producción de bebidas envasadas en botellas asépticas requería verificar la información codificada para asegurar que los datos de lote...
Reto Una empresa con ubicación en la zona metropolitana requería validar que las latas, en las que envasó sus productos, contaran con esterilización por autoclave. El proceso de...
Reto Una reconocida empresa dedicada a la producción de cerveza, localizada al norte del país, requería una solución para optimizar su proceso de codificación, debido a que utilizaba un...
Reto Una reconocida fábrica dedicada a la elaboración de salsas, con ubicación en Nayarit, que tiene una producción de entre 180,000 y 200,000 botellas diarias, las cuales exporta a Estados...
En un mundo donde la dependencia de la energía eléctrica es absoluta, las interrupciones pueden causar no sólo molestias, sino también importantes pérdidas económicas en...
El adecuado funcionamiento de los cromatógrafos de gases es crucial para garantizar la precisión y fiabilidad en los análisis de laboratorio. Estos instrumentos analíticos son fundamentales en...
Los cromatógrafos de gases son empleados en el ámbito analítico de laboratorios industriales. Su función principal es separar y analizar compuestos en diversas muestras, convirtiéndose en un pilar del...
Mantenimiento de Cromatógrafos de Gases, Servicio Indispensable para tus Equipos AnalíticosEn el mundo de la cromatografos de gases, el rendimiento y la precisión de los equipos son...
Calificación de cromatógrafos: ¿Por qué es importante?La calificación de cromatógrafos es un proceso primordial en el campo de la química analítica. Este proceso, consiste en una serie...
Pólizas de mantenimiento a cromatógrafos vs. Servicio por evento ¿Cuál es la mejor opción?La elección entre contratar pólizas de mantenimiento a cromatógrafos o un servicio...
Cromatógrafos de gases: importancia y ventajas de implementaciónEn la industria y la investigación, la calidad y el análisis preciso de diferentes muestras son esenciales. Así,...
De acuerdo con el Reglamento del RENE, mejor conocido como "Registro Nacional de Emisiones", establece que las todas las actividades productivas, comerciales o de servicios cuya operación...
Reto Una empresa ubicada en Mexicali, Baja California, especializada en dispositivos médicos, enfrenta el desafío de impresión y codificación sobre papel médico y film de plástico utilizando...
En el marcado y la trazabilidad industrial, existen dos tecnologías destacadas, por ser usadas con frecuencia en las líneas de producción: codificadores láser y...
La impresora para cartón es una herramienta útil y fundamental en la industria moderna, especialmente en el proceso de marcaje de productos. Estas impresoras codificadoras garantizan que cada...
Con el ritmo de producción más centrado en la eficiencia energética y la automatización, los cables de control desempeñan un papel clave en la optimización de los procesos industriales. Estos...
Reto Una empresa ubicada en el Estado de México, especializada en la industria farmacéutica, enfrentaba un desafío en el proceso de impresión y etiquetado: Cuando se armaban paquetes...
Reto Una compañía farmacéutica en la zona de Toluca requería optimizar su proceso de impresión en blíster de PVC y otros plásticos. El reto exigía tener una aplicación que permitiera...
La cromatografía de iones es una técnica analítica esencial que permite separar y cuantificar con precisión una amplia variedad de iones presentes en muestras complejas. Su aplicación se ha extendido...
La cadena logística actual apunta a contar con sistemas cada vez más digitales y más automatizados, en sintonía con el comercio globalizado. La tecnología también está presente en los almacenes...
La cromatografía de gases es una técnica analítica indispensable en sectores como el farmacéutico, petroquímico y alimentario, donde la precisión es un imperativa. Para asegurar la confiabilidad de...
La cromatografía de gases-masas es, en la actualidad, una de las técnicas analíticas industriales más eficaces. Esta metodología une la eficiencia de los cromatógrafos de gases y la...
Aunque los equipos de cromatografía de gases nuevos son la opción primordial considerada por los laboratorios, cuando estos buscan cambiar sus equipos; un cromatógrafo de gases...
Reto Una destacada empresa en Chihuahua, que fabrica alimentos enlatados, se enfrentaba ante un reto muy importante, ya que necesitaban marcar de manera legible e indeleble su producto, en una...
Reto Una empresa ubicada la Ciudad de México, fabricante de decorativos de temporada, requería realizar la codificación de información de sus productos y códigos de...
El análisis con cromatógrafo de gas y otros equipos de laboratorio es fundamental para garantizar la seguridad de los productos que llegan a los consumidores finales. Desde la formulación de...
La cromatografía de gases es una técnica análitica importante actualmente. Esta se utiliza en diferentes sectores, debido a los confiables resultados que ofrece en el control de calidad y el...
Emplear un cromatógrafo de gases en nuestros análisis de laboratorio, puede ser fundamental para asegurar resultados de alta precisión. Dentro del campo analítico, este tipo de equipos sobresalen...
Reto Una empresa fabricante de helados originaria de Hidalgo, tenía dificultades con sus equipos de codificación. Solían emplear un sistema de costo mínimo para el marcaje de sus...
Contratar una póliza de mantenimiento a cromatógrafos de gases es una inversión que toda empresa analítica debe contemplar. Usualmente, los cromatógrafos cuentan con una garantía inicial que ofrece el...
Reto Una reconocida empresa en el centro del país, que se dedica a la fabricación de productos avícolas, ha utilizado variedad de tecnologías Domino en sus producciones desde...
Reto Una reconocida fabrica de bebidas gasificadas al norte de México, enfrentaba un reto importante en codificado. Los lapsos de detenimiento en la productividad eran largos, las...
El cucharón para polvos que fabricamos en Termofijos y Termopláticos, está hecho con material atóxico. el diseño es elegante, tiene un mango que termina con un pequeño doblez de manera que...
Reto Una reconocida empresa de la industria de bebidas, que se localiza en el estado de Chihuahua, requería hacer una actualización de su tecnología de impresión...
Reto Una reconocida empresa, ubicada en el occidente, que fabrica productos de belleza, lidiaba con un reto complicado: imprimir en tubos metálicos, la información e instrucciones de uso de sus...
Los variadores de frecuencia (VFD, por sus siglas en inglés) son dispositivos esenciales en la industria moderna, ya que permiten controlar la velocidad y el torque de motores eléctricos,...
Reto Una reconocida empresa productora de artículos para higiene y cuidado personal, quería optimizar su proceso de impresión, ya que trabajaban con equipos de tinta de marcas...
Reto Una destacada empresa del área metropolitana, que fabrica guantes de plástico para limpieza, deseaban optimizar el codificado de sus productos. Este proceso debía realizarse a una velocidad...
Los reactivos analíticos son sustancias químicas de alta pureza utilizadas para identificar, medir o analizar componentes específicos en muestras, garantizando resultados precisos y confiables....
En la industria moderna, la trazabilidad de los productos es esencial para asegurar su calidad, seguridad y cumplimiento de las normativas vigentes. Para ello, la codificadora industrial se ha...
A lo largo de los años, la tecnología de codificación ha evolucionado para adaptarse mejor a las necesidades cambiantes de la industria. Los avances en las tecnologías de impresión han permitido que...
Estamos muy contentos por anunciarles que los productos Elitech ahora forman parte de nuestras líneas para HVAC/R:Termómetros Manómetros y herramientas HVAC/R Paneles de control Controladores de...
Nos alegra informarles que ahora la línea Wipcool forma parte de nuestro Catálogo de Productos con una selección en:Bombas de condensadoBombas de vacíoEquipo para limpieza y...
En un entorno donde la trazabilidad es una prioridad, la implementación de sistemas de serialización es fundamental. Estos sistemas permiten registrar información clave sobre cada unidad de producto,...
Reto Una destacada empresa en la región central de México, fabricante de productos para el cuidado personal, presentaban dificultades con sus codificadoras láser de otra marca, ya...
Proteger a las personas y asegurar la continuidad operativa de un inmueble ante un incendio depende, en gran medida, de contar con los equipos y sistemas contra incendios adecuados. Cada edificio...
La seguridad en inmuebles industriales, comerciales o institucionales no debe estar comprometida. Por eso, uno de los elementos más importantes para proteger vidas humanas y activos materiales ante...
El mantenimiento de los variadores de frecuencia ya no es solo una medida correctiva. Es una estrategia técnica y operativa que impacta directamente en la productividad, eficiencia energética y...
Reto Una empresa de la industria alimentaria, en Zapopan, necesitaba una solución para la codificación de sus productos en empaque flexible, tecnología a implementar en todas sus líneas...
La limpieza de ductos de aire acondicionado destaca como una de las tareas más estratégicas, para garantizar un correcto funcionamiento y durabilidad de los sistemas HVAC en oficinas, industrias,...
En la actualidad, la climatización juega un papel esencial en la industria, el comercio y las áreas residenciales, como parte de un entorno más agradable y confortable. La limpieza de ductos de aire,...
Reto Una empresa de manufactura de componentes electrónicos y conectores, en Tamaulipas, requería una actualización de su estación de codificado, lo que le permitiría contar con...
Reto Una fabrica de productos quirúrgicos que radica en el Estado de México, necesitaba una solución para el codificado de cajillas de suturas en su área de aplicaciones y llenado....
Invertir en la tecnología correcta de cadena de frío no es solo una decisión técnica, sino estratégica. Las cámaras de refrigeración, cámaras de congelación o un cuarto frío bien diseñado...
Nada detiene más una operación industrial que una falla en la comunicación entre equipos. Por eso, los cables de control son el corazón de la automatización moderna. Los cables de control ...
En los laboratorios industriales, de investigación, farmacéuticos y petroquímicos, los cromatógrafos son instrumentos críticos del análisis químico. Estos equipos trabajan con precisión...
En el contexto urbano actual, la integración de la naturaleza en los espacios públicos se ha convertido en una tendencia para mejorar la calidad de vida de los ciudadanos. El mobiliario urbano...
En la actualidad, el diseño del mobiliario urbano en México está evolucionando hacia una mayor inclusividad y accesibilidad, con el objetivo de crear espacios públicos que sean acogedores y...
Reto Una empresa fabricante de dulces en el norte de México, requería una solución para imprimir dos líneas de información sobre film plastificado, a una velocidad de 2,000 piezas por...
La eficiencia energética y la continuidad operativa son prioridades en los procesos industriales. Sabemos que cuando se detiene un equipo, la producción no espera. Por eso, desde...
Reto Una empresa de Jalisco, que elabora bebidas saludables sin sodio ni azúcares, enfrentaban el reto de codificado en latas de aluminio. Necesitaban un equipo que brindara calidad de impresión...
Las cámaras de congelación son estructuras térmicamente aisladas diseñadas para mantener productos a temperaturas bajo cero, durante períodos prolongados. Son fundamentales en la industria...
Los cuartos fríos industriales ya no son una opción secundaria: se han convertido en infraestructura esencial para empresas de alimentos, farmacéuticas, químicas y logísticas. Estas estructuras,...
Reto Una empresa de pesticidas en Hidalgo enfrentaba problemas con el codificado de sus envases de 1 litro en polietileno de alta densidad. Sus equipos anteriores no ofrecían buena adherencia ni...
En la automatización industrial moderna, la comunicación entre variadores de frecuencia y sistemas de control es esencial para lograr eficiencia, monitoreo en tiempo real y respuestas...
Reto Latinoamérica destaca por su dinamismo, crecimiento sostenido y fuerte enfoque exportador. Sin embargo, las empresas de la región enfrentan desafíos comunes en codificación y marcaje:...
Determinar la frecuencia adecuada del mantenimiento de cromatógrafos de gases es clave para evitar paros inesperados, asegurar la calidad de los resultados y cumplir con normativas nacionales e...
Seleccionar un proveedor de servicios para cromatógrafos de gases debe ir más allá del precio. La experiencia técnica, el conocimiento de distintas marcas y la capacidad de respuesta son elementos...
El mantenimiento de un cromatógrafo de líquidos requiere conocimiento técnico preciso y experiencia con distintos fabricantes y configuraciones. Muchos laboratorios, en busca de reducir costos,...
El mantenimiento preventivo de cromatógrafos de líquidos se basa en la programación periódica de revisiones técnicas para evitar fallas antes de que ocurran. Por otro lado, el mantenimiento correctivo...
En Combramex sabemos que los variadores de frecuencia son piezas clave para la eficiencia y confiabilidad de procesos industriales. Sin embargo, su correcto funcionamiento...
Reto En Torreón, una empresa de alimentos necesitaba imprimir logotipos en el exterior de tapas plásticas y, al mismo tiempo, aplicar codificación alfanumérica en su parte interna, representando...
Una póliza de mantenimiento para cromatógrafos no es solo una inversión en tu equipo, sino también en la continuidad y calidad de tus procesos analiticos. Si eres responsable de laboratorio o...
En la operación industrial moderna, el variador de frecuencia en la automatización se ha convertido en el corazón de múltiples procesos. Sin embargo, cualquier falla, desajuste o paro imprevisto...
La calificación operacional (OQ) es un proceso clave en el ciclo de vida de un cromatógrafo. Este garantiza que el equipo funcione de acuerdo con las especificaciones definidas por el fabricante...
Una póliza de mantenimiento para cromatógrafos es una solución estratégica para laboratorios e industrias, que buscan asegurar la continuidad operativa de sus equipos de análisis....
La calificación de desempeño (PQ) es una etapa en el proceso de validación de equipos de cromatografía HPLC, GC e IC. En esta fase, se confirma que el sistema cumple...
El mantenimiento preventivo en un cromatógrafo HPLC es una práctica esencial para garantizar la exactitud de los análisis y la confiabilidad de los resultados. Principalmente, en...
El uso de cromatógrafos en la industria moderna exige un enfoque integral de servicio, que vaya más allá de simples revisiones técnicas. Para garantizar el máximo rendimiento de...
El servicio técnico de cromatógrafos es un factor determinante en el desempeño de los laboratorios y en la confiabilidad de los procesos de análisis. Un equipo de cromatografía que no...
En la última década, los drones industriales se han convertido en aliados estratégicos para sectores como seguridad, construcción, telecomunicaciones, transporte e ingeniería civil. Hoy, las...
En DG Electronics llevamos una importante trayectoria acercando a las empresas la tecnología más avanzada en drones industriales DJI, equipos diseñados para transformar la seguridad, la inspección y...
El mantenimiento para cromatógrafos es un pilar esencial en laboratorios y centros de investigación. Este servicio garantiza que los instrumentos de cromatografía operen con la...
En los últimos meses del año, muchas empresas comienzan a cerrar ciclos de producción y preparar sus líneas para el arranque del siguiente periodo. Este es el momento ideal para aplicar un...
En la automatización industrial moderna, los variadores de frecuencia son esenciales para controlar motores eléctricos, optimizar el consumo energético y mantener la eficiencia del...
En cada uno de nuestros proyectos —ya sea una cámara de refrigeración, cámara de congelación o un cuarto frío industrial— combinamos tecnología, diseño y eficiencia para brindarte una solución...
El agua potable es un recurso vital, y garantizar su seguridad es una prioridad mundial. Organismos como la OMS y la EPA han establecido límites claros para contaminantes iónicos y subproductos de...
El crecimiento del consumismo a nivel mundial ha provocado un aumento acelerado en la generación de residuos de empaque, hoy representan una parte significativa de la basura global. El auge del...
La confiabilidad de las tarjetas electrónicas (PCBA) es crítica para industrias como la automotriz, médica y de telecomunicaciones. En estos sectores, un fallo por contaminación iónica puede...
El mantenimiento preventivo para cromatógrafos es un servicio esencial para asegurar el funcionamiento óptimo de los equipos analíticos de líquidos (HPLC), gases (GC) o iones (IC). En...
El mantenimiento correctivo es una medida técnica indispensable, cuando el desempeño de un cromatógrafo comienza a mostrar fallas respecto a su operación habitual. A diferencia del...
En los laboratorios analíticos, el mantenimiento preventivo se posiciona como una estrategia clave para garantizar el rendimiento técnico de los equipos. Esto, considerando que la precisión...
La calificación de instalación (IQ) se ha consolidado como el primer paso para la validación de los cromatógrafos, debido a que garantiza que este se instale conforme a las...
En los laboratorios industriales y de investigación, el tiempo es un recurso valioso. Cada minuto que un cromatógrafo permanece fuera de servicio puede representar pérdidas económicas, retrasos...
Una empresa ubicada en el Estado de México, especializada en la fabricación de chocolates para distintas marcas y cadenas de autoservicio, necesitaba renovar su sistema de codificación. Cuentan...
El sector avícola ha estado en crecimiento, aumentando las regulaciones de la seguridad alimentaria. Para poder garantizar la trazabilidad de cada huevo es una necesidad clave para productores...
Importancia de Certificar tus Equipos para Izaje de CargasHoy en día, los elementos de izaje son herramientas de suma importancia para la industria, ya que ayudan a optimizar tiempos de...
En la metalmecánica y la metalurgia, la limpieza y preparación de superficies es un paso crítico para garantizar la calidad de piezas, recubrimientos y procesos posteriores como el pintado,...
El cromatógrafo de gases (GC) es uno de los instrumentos analíticos más confiables y versátiles en laboratorios de investigación, control de calidad y procesos industriales. Sin...
Los cromatógrafos de gases son herramientas fundamentales en laboratorios industriales, pero requieren un mantenimiento preventivo adecuado para operar con precisión. Un programa...
La creciente demanda de energía confiable en México ha convertido a las plantas de emergencia diésel en un componente indispensable para industrias, telecomunicaciones, infraestructura crítica,...
La calificación y el mantenimiento documentado de cromatógrafos de laboratorio no son solo requisitos técnicos: son herramientas estratégicas que garantizan la continuidad operativa y el...
Guía NAFA para centros de datos: buenas prácticas de filtración de aire para infraestructura de TI La calidad del aire dentro de un centro de datos no es un detalle operativo; es un determinante...
En los laboratorios analíticos y de control de calidad, los cromatógrafos de gases son equipos esenciales para obtener resultados precisos y confiables. Sin embargo, como cualquier instrumento...
Los fabricantes están adoptando cada vez más los códigos 2D en sus etiquetas y empaques debido a los beneficios que ofrecen, como trazabilidad, protección contra falsificaciones y una conexión...
La cromatografía iónica ha dejado de ser una técnica especializada para convertirse en una herramienta analítica estratégica en múltiples industrias. Los compradores de estos sistemas no solo...
Elegir el cromatógrafo de gases adecuado puede marcar la diferencia entre un laboratorio eficiente y uno con resultados inconsistentes o sobrecostos operativos. Con tantas configuraciones y...
En 1996 se funda PRODUCTOS QUÍMICOS DE SALTILLO con el objetivo de atender a las industrias de la región como la Automotriz, Metalmecánica, Farmacéutica, Tratamiento de Aguas, Minera,...
En la actualidad, donde la precisión y la trazabilidad son esenciales en cualquier proceso analítico, la cromatografía iónica se ha consolidado como una de las técnicas más poderosas para la...
Si bien en años recientes las lámparas ultravioleta germicidas (UVC) han cobrado mayor atención, no es una tecnología nueva. Su uso en la inactivación de microorganismos cuenta con más de un...
La calidad del aire en espacios interiores es un factor clave para la salud y el bienestar en hogares, oficinas, escuelas y otros espacios cerrados. La Agencia de Protección Ambiental de Estados...
Muchas personas creen que al tener un minisplit en casa u oficina el aire que respiran es más limpio. La realidad es que estos equipos controlan la temperatura, pero no eliminan los...
La manufactura en la actualidad exige procesos rápidos de producción, confiables y eficientes. En este contexto, la codificación y el marcado son etapas importantes, ya que cualquier falla puede...
En la cromatografía de líquidos moderna, HPLC y UPLC son dos tecnologías ampliamente utilizadas para la separación, identificación y cuantificación de compuestos químicos. Aunque comparten el...
Importancia del Mantenimiento de Aire AcondicionadoComo es bien sabido, los seres humanos debemos tener una atención a nuestra salud y bienestar constante. Esto mismo se puede...
En una planta de producción de bebidas, la precisión en la dosificación de ingredientes líquidos es crítica. Por ejemplo, al elaborar jugos o refrescos, un error en la cantidad de concentrado, agua o...
QHSE, SARI® y resiliencia operativa con la que hacemos química rumbo a 2026En Chemlogis, hacer química significa articular técnica, procesos y personas para sostener la operación con...
El ácido acético glacial es uno de los insumos más utilizados como acidulante, regulador de pH y agente antimicrobiano en la industria alimentaria. Sin embargo, al tratarse de una sustancia...
La cromatografía iónica (IC) es una técnica clave para la determinación de aniones y cationes en agua potable, descargas, emisiones y ambiente laboral. En muchos laboratorios, sus resultados...
La industria del huevo enfrenta una creciente presión por mejorar la trazabilidad, mantener altos volúmenes de producción y adaptarse a múltiples formatos de empaque sin perder eficiencia. En...
Aunque tu equipo esté perfectamente calibrado, si las columnas cromatográficas no se encuentran en condiciones óptimas, el resultado analítico se verá afectado.Monitorear ciertos...
En la industria cervecera, mantener un codificado preciso y confiable es clave para garantizar trazabilidad, cumplimiento normativo y eficiencia operativa. La reconocida cervecera alemana...
En la industria electrónica, la limpieza de tarjetas electrónicas ensambladas (PCBA, Printed Circuit Board Assembly) garantiza confiabilidad, durabilidad y desempeño eléctrico. Residuos iónicos...
La industria alimentaria opera bajo uno de los esquemas regulatorios más estrictos del sector industrial. La presencia de contaminantes en niveles traza puede representar riesgos sanitarios,...
Una empresa de la industria automotriz ubicada en Guanajuato enfrentó un incremento significativo en la demanda, derivado de un nuevo proyecto.Para cumplir con los tiempos...
En México, el monitoreo ambiental requiere cada vez mayor precisión, trazabilidad y cumplimiento regulatorio. Para lograrlo, muchos laboratorios de análisis ambiental operan bajo acreditación de...
En sectores como el alimenticio, farmacéutico y comercial, contar con un sistema de refrigeración eficiente no es una opción, sino una necesidad. Loscuartos fríos se han convertido en una...
En un entorno empresarial moderno, contar con un sistema de aire acondicionado bien diseñado e instalado ya no es un lujo, sino una necesidad que impacta directamente en la eficiencia operativa, el...
En el mundo de la codificación industrial existen múltiples tecnologías, y entender sus diferencias es clave para tomar una decisión acertada. En nuestra región, donde las industrias exigen...
El análisis de aromas en alimentos, bebidas, farmacéutica, fragancias y química fina es un campo clave para garantizar calidad, diferenciación y competitividad. El cromatógrafo de gases...
El color es un atributo crítico en múltiples industrias, especialmente en alimentos, bebidas, cosméticos y materiales. No solo influye en la percepción del consumidor, sino que también puede ser un...
En entornos analíticos, la confiabilidad de los resultados depende no solo de la tecnología empleada, sino también de la disciplina operativa. Aplicar Buenas Prácticas de Laboratorio (BPL) en el...
En entornos regulados, la confiabilidad de los resultados analíticos no es negociable. La validación y calibración de cromatógrafos de gases (GC) son procesos esenciales para garantizar la...
La industria HVACR en México está evolucionando hacia un enfoque que integra eficiencia técnica con bienestar social. Durante la gestión de Paula Segovia, como presidenta de ASHRAE Capítulo...
En la operación diaria de laboratorios, el reemplazo de refacciones en cromatógrafos es inevitable. Sin embargo, una de las decisiones más críticas es elegir entre refacciones originales y...
Un cromatógrafo de gases (GC) impacta directamente en la precisión analítica, la continuidad operativa y el cumplimiento normativo de los laboratorios. Sin embargo, muchos equipos reducen su...
En laboratorios donde la continuidad operativa es crítica, una falla en un cromatógrafo puede representar retrasos, pérdida de productividad y riesgos en la calidad analítica. Por ello, contar con una...
Los costos operativos asociados a cromatógrafos de gases, cromatógrafos de líquidos y cromatógrafos de iones pueden incrementarse rápidamente si no existe una estrategia...
La evolución de la trazabilidad y la digitalización en manufactura está impulsando una nueva etapa en el codificado industrial. Con la evolución de estándares...
Un cromatógrafo de líquidos (HPLC) puede continuar operando incluso cuando algunos de sus componentes comienzan a presentar desgaste. Sin embargo, ignorar las primeras señales de falla puede afectar...
Mantente informado con las últimas noticias de los proveedores del sector Metrología, Análisis y Control.
Ciudad de México, Méx.; 14 de junio de 2022 - EXPO PACK México 2022 (14-17 de junio; Expo Santa Fe), la exposición más grande de su tipo en América Latina regresa a México por primera vez en...
El pasado 17 de junio del presente año, Climaproyectos festejó dos acontecimientos importantes para la empresa junto a sus directivos, las marcas con las que colaboran y sus trabajadores.Por un...
Registrate enviando un mail a: [email protected]:30:00 - 12:30 PMDr. Amauris Hechavarria/ PS Analytical.1. Introducción general2.Fundamentos básicos por espectroscopia de fluorescencia...
Arrendamiento Puro (Valor Justo de Mercado): Esquema de financiamiento de rentas atractivas, dirigido a clientes que desean actualizar regularmente la tecnología y ahorrar costos. Cuando finaliza un...
¿Estás buscando actualizar tu equipo de computación? ¿Necesitas accesorios nuevos o consumibles para mantener tu dispositivo funcionando de manera óptima? ¡Estás en el lugar correcto! Tenemos todo lo...
En un mundo donde la tecnología avanza a pasos agigantados, la adquisición de equipos de cómputo de calidad se convierte en una necesidad imperante tanto para empresas como para hogares. En este...
VENTAJAS DE LA TUBERÍA POLIESTER REFORZADA CON FIBRA DE VIDRIO / TUBERÍA DE FIBRA DE VIDRIO / TUBERIA DE FRP:MantenimientoNo requieren mantenimiento por corrosión o humedad al ser...
En julio de 2024 presentamos a Distribuidores, Integradores y Contratistas de la industria de la refrigeración, los equipos para refrigeración Hispania. Visitamos 10 ciudades de la República Mexicana,...
¿Qué significa “cosmética consciente”?🌍 Como maquiladores fabricantes, para nosotros, la cosmética consciente va más allá de una tendencia: es una responsabilidad.Significa:🔹 Elegir ingredientes...
Obtubimos la acreditación por la EMA para realizar servicios de calibración de instrumentos de medición en el área de temperatura y humedad, así como en calificación de equipos y áreas, mapeos de...
¿Qué es SARI®?Un sistema de gestión que implementa protocolos mediante 240 requisitos para mejorar de manera continua la salud, la seguridad y la protección ambiental de las empresas en la...
Muchas personas, al recibir una receta médica, se preguntan si un medicamento genérico “sirve igual” que uno de patente. Esta duda es completamente normal, especialmente cuando se trata de la salud...
En un entorno empresarial donde la continuidad operativa y el control de costos marcan la diferencia, contar con una planta de generación energética confiable es clave. Las empresas necesitan...
Conoce las experiencias de los proveedores del sector Metrología, Análisis y Control al implementar sus productos y servicios.
Valoro la practicidad y efectividad.El llegar a más clientes.Hemos incrementado la cartera de clientes.Hemos logrado concretar ventas a través de Cosmos Online.Recomiendo Cosmos por ser una Plataforma...
Cosmos es fácil de gestionar y proporcionan buenos datos de los clientes que quieren contactarteObtenemos diariamente de 2 a 3 prospectos calificados.Los recomiendo porque es un portal donde los...
Si lo que necesitas son equipos para tu centro de lavado tenemos el ideal para ti, conoce nuestros modelo de regulador de voltajeR-AVR 2408 / R-AVR 3008.¡Si necesitas calidad en protección de...
Sector: servicios de montaje, mantención, chequeo y calibración de instrumentación y válvulas de proceso multimarca. ...
Con la implementación de diversos productos de marcaje por láser e impresión ayudamos a Victory Brewing company a cumplir con las exigencias de sus clientes. En Domino no solo les dimos las...
Mediante el uso de la Serie Ax de Domino, Omega Design Corporation ha mejorado sus procesos en la serialización de medicamentos. El proceso de empaque en relación al sector farmacéutico cobra gran...
Blini, empresa de origen francés, eligió a Domino como su aliado en procesos de marcaje y codificación para sus “blinis”. Con el empleo de impresoras de la Serie Ax de Domino se aumenta la precisión...
Los equipos de marcaje e impresión de Domino resultan en un nivel de fiabilidad adecuado a diferentes industrias, como lo es el caso de Express Packaging, que, mediante el empleo del plan “Relax”...
Domino ha ayudado a muchas empresas, como Branca, a alcanzar estándares de calidad adecuados para cumplir con los marcos normativos de su sector industrial. A través de la innovación tecnológica...
Mediante la innovación en impresoras y codificadoras de la Serie Ax, Domino ha ayudado a mejorar los procesos de codificación en los productos de Sovena, empresa portuguesa que empaca sus...
Con la implementación de tecnologías Inkjet y laser de Domino, DEYUSA ha ampliado su productividad hasta un 30% lo que sumado a su excelente calidad de productos le ha abierto fronteras para...
Conoce como A&N Alimentos ha logrado satisfacer a sus clientes a través de un elevado control de calidad para el cual eligieron equipos de impresión y codificadoras de Domino. A&N Alimentos ha...
Presicion Works es un cliente que gracias a los equipos de impresión de Domino ha podido aumentar la velocidad en la que manufactura sus productos, en este caso, arneses eléctricos. En Precisión Works...
Con la introducción de impresoras y codificadoras, con tecnología láser y de tinta, en las líneas de producción de Mega Alimentos, Domino les ha brindado la seguridad de que los procesos no...
Te invitamos a conocer el testimonio de Galletas Dondé, empresa yucateca con más de 115 años de experiencia en la fabricación de galletas y pastas, tienen una producción de 130 toneladas...
Suministro, Instalación y arranque de bombeo velocidad constante y presión constante, tren de filtración (zeolita, carbón y suavizador), sistemas UV y tuberías.Capacidad: 150 gpm Bombeo, 100 gpm...
Excelente trato y atención con aclaración de dudas, propuestas por necesidades específicas, formalidad en tiempo de entrega y envío.
Certificate of Registration STAREGISTERCertifica que, tras una satisfactoria auditoría, se ha determinado que el Sistema de Gestión SistemPack (Sistemas de Empaque Industrial S de RL de CV) situado en...
Conoce las dudas más frecuentes de los productos y servicios del sector Metrología, Análisis y Control.
Busco almacenaje y distribución de productos congelados y refrigerados, y que...
Estimado Ricardo Ortiz,
Te compartimos que tu pregunta se ha enviado de...
Quisiera saber qué significa el codigo de Error E7 en un minsplit Prime modelo...
Estimado Luigi C,
El código de error E7 en un minisplit...
¿Tendrán la ficha técnica de una planta de emergencia marca Coleman...
Estimado Cristian Guerrero,
Te compartimos que tu pregunta se ha enviado...
Busco la tarjeta del evaporador para aire acondicionado...
Estimado Manuel Garcia,
Te compartimos que tu pregunta se ha enviado de...
Estimado Miguel Cortes,
Te compartimos que tu pregunta se ha enviado de...
Estimada Alesandra Benvenuttp,
Te compartimos que tu pregunta se ha...
Estimado Jesus Gómez,
Te compartimos que tu pregunta se ha enviado de...
Da clic en el producto de tu interés y accede a información de proveedores e información detallada del producto.